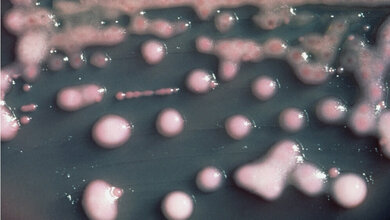
K. pneumoniae

Der wichtigste Baustein des Biofilms - das Protein TasA - wird überraschenderweise bereits im Zellinneren vorgeformt. Gelangt TasA nach außen, bilden diese Bausteine längere Ketten, sogenannte Fibrillen, die wie ein Grundgerüst bzw. Mauern den Biofilm stabilisieren.
Biofilme können auch für den Menschen eine Gefahr darstellen, da sie Krankheitserregern Schutz vor den Waffen des Immunsystems und Antibiotika bieten. Um die Ausbildung von Biofilmen zu hemmen und die Wirksamkeit von Antibiotika zu garantieren, ist es notwendig, die Struktur der Bausteine zu kennen.
TasA ist ein überraschend dynamisches Protein
Auf Anregung des B. subtilis-Experten Kürşad Turgay von der Universität Hannover haben die Berliner Forscherinnen die molekulare Struktur des wichtigsten Proteins in diesem Biofilm, TasA, nun gelöst. Anne Diehl aus der von Hartmut Oschkinat geleiteten Abteilung „NMR-unterstützte Strukturforschung“ des Leibniz-Forschungsinstituts für Molekulare Pharmakologie (FMP) startete mit der Produktion von TasA und studierte die verschiedenen Erscheinungsformen des Proteins, die leicht ineinander übergehen.
Dabei tat sich dafür eine unerwartete Hürde auf: „Ich habe in den 32 Jahren meiner Berufstätigkeit auf dem Gebiet der Proteinstrukturforschung noch nie mit einem so dynamischen Protein gearbeitet. Bereits nach kurzer Zeit lagern sich die löslichen TasA-Proteine zusammen und erzeugen einen Gelee-artigen Zustand“, so Anne Diehl im Rückblick auf die erfolgreiche Charakterisierung der einzelnen Zustände.
Ein robuster Kern mit flexiblen Schlaufen
Einen möglichen Grund fand Yvette Roske aus der Abteilung „Makromolekulare Strukturen und Interaktionen“ des Max-Delbrück-Centrums für Molekulare Medizin (MDC), geleitet von Udo Heinemann. Ausgehend von frisch gereinigtem TasA züchtete sie Kristalle, analysierte diese mittels hochenergetischer Röntgenstrahlung am BESSY in Berlin-Adlershof und entschlüsselte so die dreidimensionale Faltung des Proteins.
„Es zeigte sich, dass die Struktur von TasA in weiten Bereichen hoch geordnet ist. Ein großer Anteil an ß-Faltblatt-Elementen verleiht dem Protein einen robusten Kern, der jedoch mit flexiblen Schlaufen dekoriert ist“, fasst Yvette Roske ihre Erkenntnisse zusammen.
Interessanterweise gehört die Aminosäure Arginin nicht zu den Bestandteilen von TasA. Durchschnittlich bestehen Proteine zu 10 % aus dieser basischen Aminosäure, das ist doppelt so viel, wie eine statistische Verteilung aller 20 vorkommender Aminosäuren erwarten lässt. „Dass ein Protein gänzlich auf diesen Grundbaustein verzichtet, muss einen Grund haben“, erläutert Anne Diehl.
Arginin dient häufig als Ansatzpunkt für Proteasen - Enzyme, die andere Proteine zerschneiden. Die Abwesenheit von Arginin erklärt möglicherweise die außerordentliche Stabilität von TasA gegenüber Proteasen und macht dieses Protein damit zu einem robusten Stützpfeiler des schützenden Biofilms.
TasA könnte erklären, warum Bacillus subtilis nicht pathogen ist
Dabei ähnelt die Aminosäureabfolge in TasA einer Protease mit Namen Camelysin, die viele pathogene Bacillus-Stämme an Stelle von TasA als Grundgerüst für ihre Biofilme nutzen. Die Struktur von TasA erlaubte daher die Konstruktion eines Modells für Camelysin. „Unser Strukturmodell für Camelysin zeigt, dass die dreidimensionale Faltung der beiden Proteine mit hoher Wahrscheinlichkeit sehr ähnlich ist“, sagt Yvette Roske. Doch während das Camelysin des Milzbrand-Erregers B. anthracis eine Protease ist, fehlt dem TasA des harmlosen B. subtilis diese Eigenschaft. TasA scheint im Laufe der Evolution diese enzymatische Aktivität und damit seine Pathogenität verloren zu haben.
Die Erforschung der Biofilme geht nun in die nächste Phase. Mit Hilfe der Festkörper-NMR konnten die Teams vom FMP und MDC bereits zeigen, dass sich zuvor ungeordnete flexible Teile von TasA neu ausrichten, wenn sich die Bausteine zu Fibrillen zusammenlagern. Weitere Untersuchungen der Fibrillen sollen dazu beitragen, die Stabilität der Biofilme besser zu verstehen und vielleicht sogar neue Ansätze im Kampf gegen Krankheitserreger zu finden. (idw, red)
Anne Diehl, Yvette Roske, Linda Ball, et al.: Structural changes of TasA in biofilm formation of Bacillus subtilis. PNAS, 12. März 2018, DOI: 10.1073/pnas.1718102115.
Artikel teilen